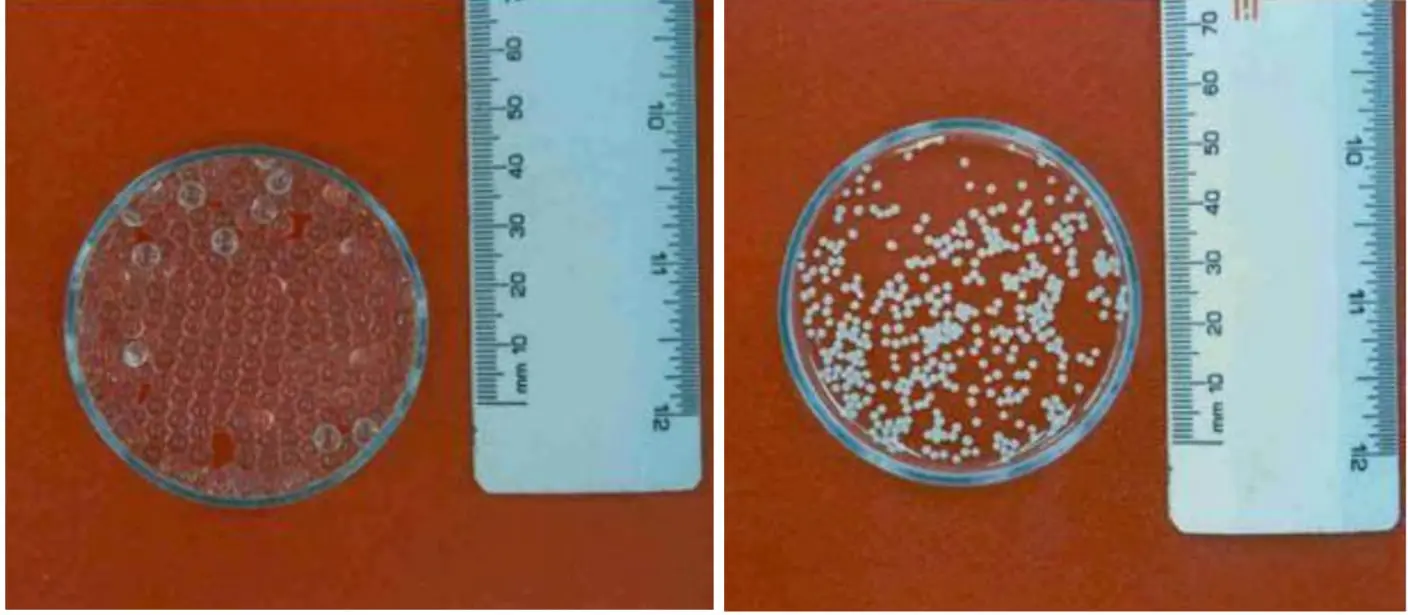
Sıcaklığa Duyarlı- TLUSHM

ABOUT US
Professional services for your research
Our company carries out interdisciplinary activities related to many engineering branches from food engineering to civil engineering, from bioengineering to physics and chemical engineering. In particular, the design of new and original composite materials, R&D and innovation-based studies are brought together and developed with 33 years of academic experience.